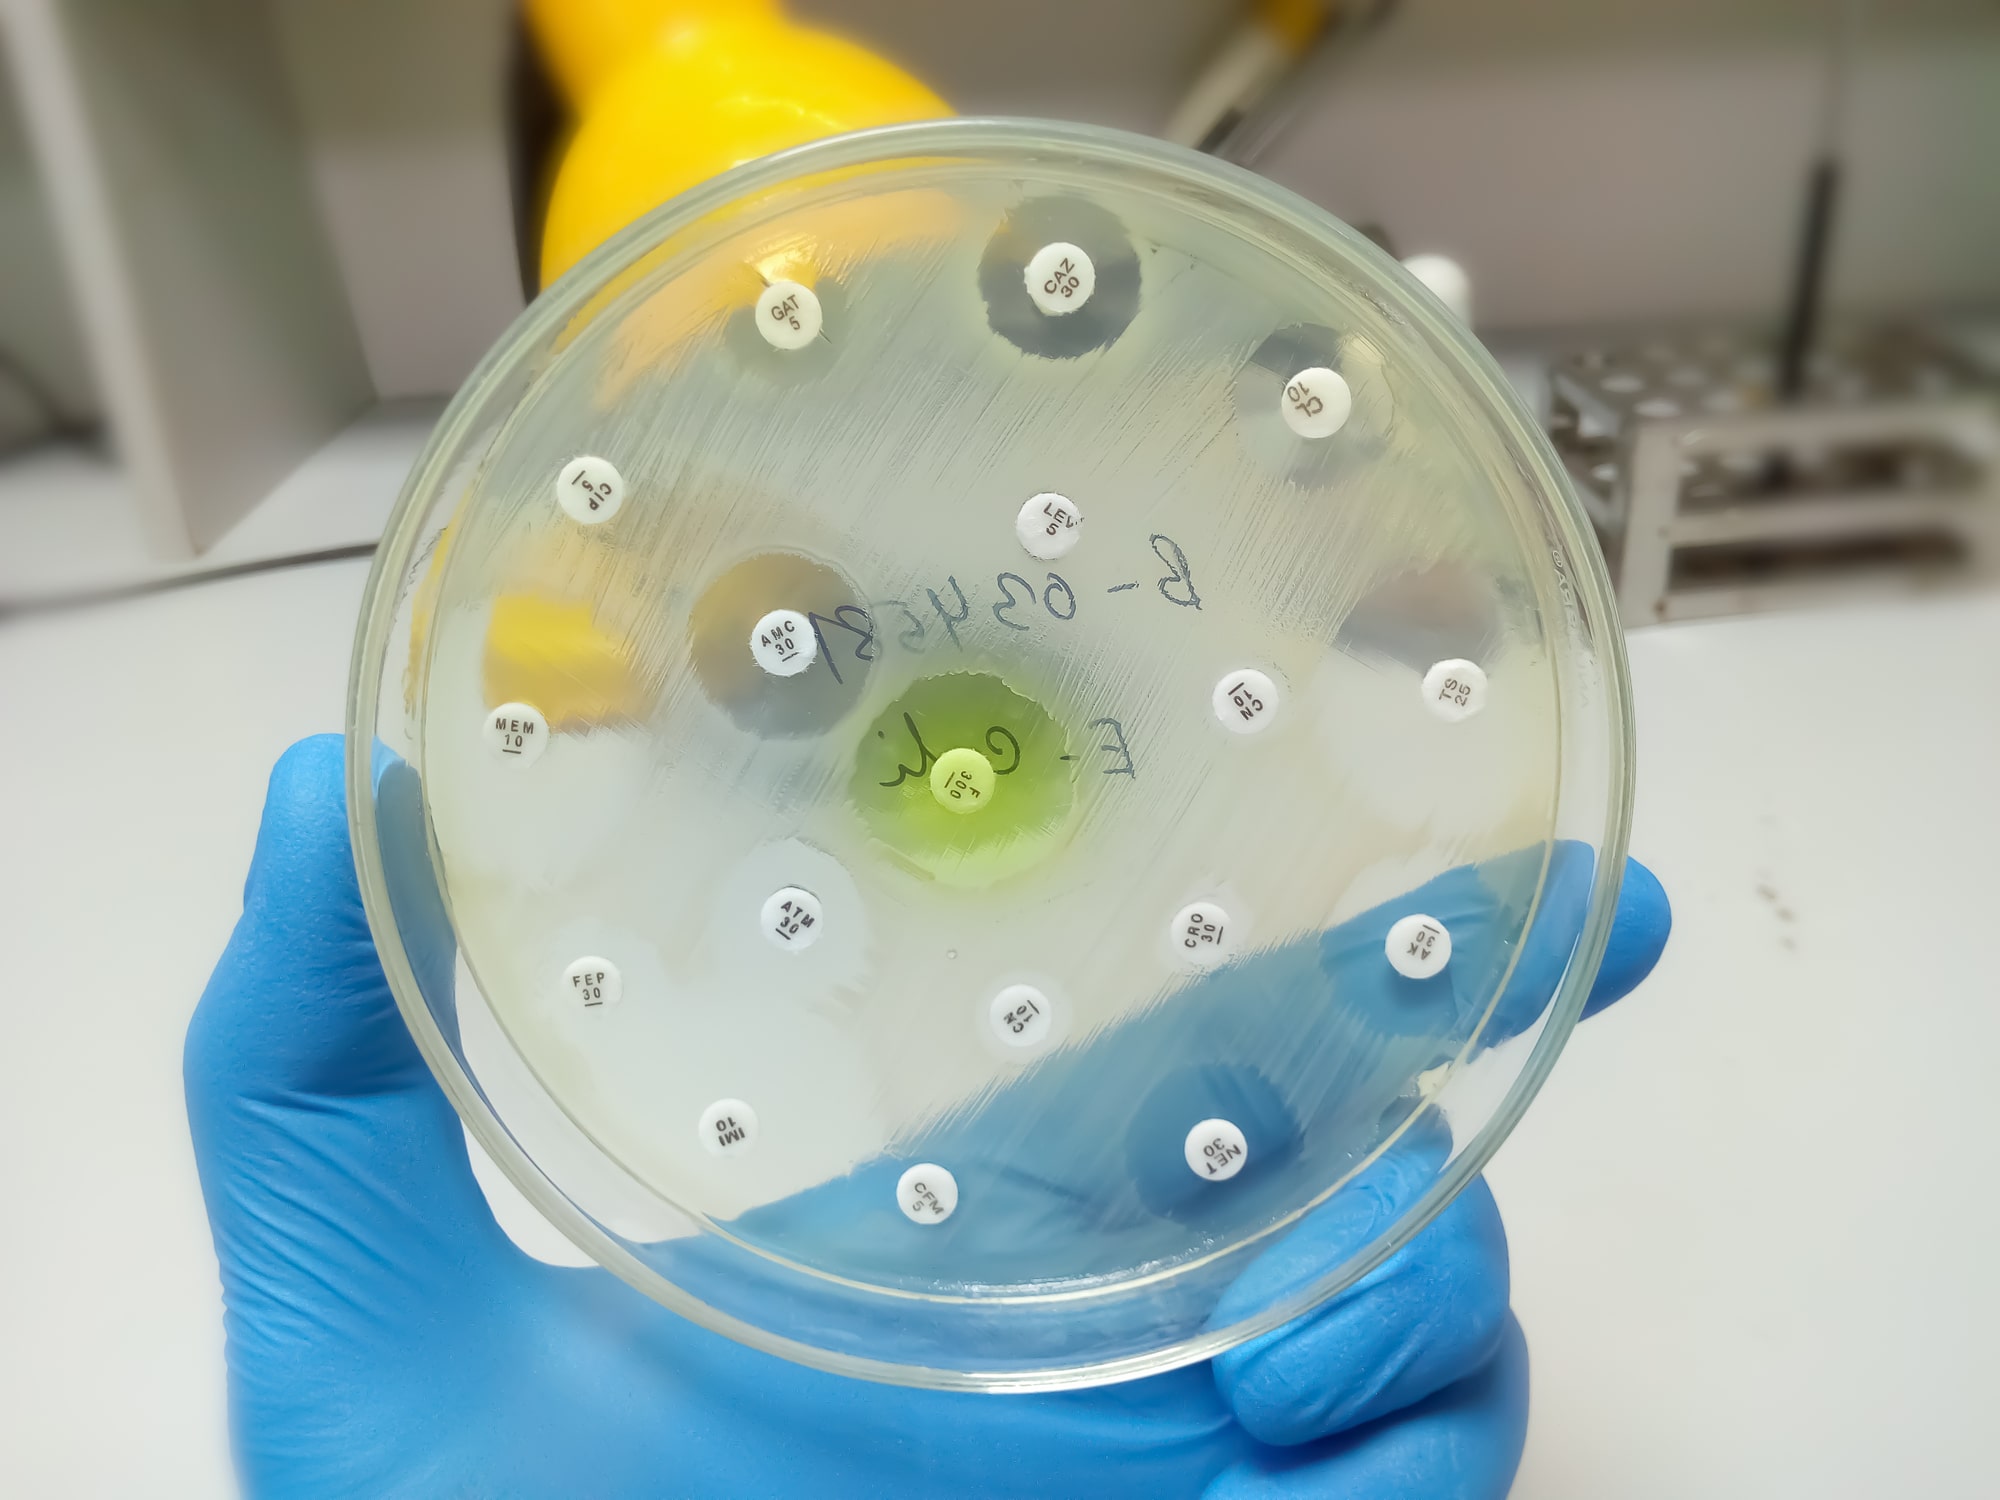

Use Cases :
Real Research, Real Impact
Use Cases: Real Research, Real Impact
Stories from our Clients
At Nonte, we’ve had the privilege of supporting groundbreaking research across disease areas, institutions, and study designs. These stories reflect the depth and flexibility of our platform, and the trust our partners place in us.
Whether you’re managing a single-site pilot or a multi-institutional program, we’re excited to bring that same expertise, care, and commitment to your study. Let’s explore what we can build together.




Neurology Research from Clinic to Cohort
Capturing longitudinal neurodegenerative data directly from a specialty clinic into a centralized research environment.
-
Ingests EMR data while preserving clinical structure
-
Supports complex CRF design reflecting real-world value sets
-
Enables transparent reporting across hospital and research workflows
Discover how we support clinical integration
Decentralized Trials for Parkinson’s Disease
Unifying data from wearables, EMRs, and CRFs in a decentralized trial setting.
-
Combines app-based, EMR, and manual data inputs
-
Builds interoperable datasets for remote participants
-
Streamlines compliance and analysis in DCT environments
Learn how we simplify remote trial data








Inter-Provincial Oncology Biobank Collaboration
Managing specimens and data across four biobanks and three genomics labs in different provinces.
-
Tracks samples from intake to sequencing
-
Supports distributed lab processes and data access
-
Provides a searchable specimen registry across all study sites
See how we connect biobanks to research goals
Antimicrobial Resistance Research at Scale
Supporting a five-institution, NIH-funded program with microbiome, omics, and process tracking tools.
-
Manages metadata, logistics, and multi-step lab workflows
-
Provides specimen ID and storage traceability
-
Organizes lab metadata for downstream analysis and sharing
Explore how we support complex study ecosystems

Longitudinal CDiff Surveillance Across 50 Sites
From legacy systems and REDCap to seamless, centralized lab and CRF data.
-
Migrates historical and current clinical-lab data
-
Supports multi-year study structures and process changes
-
Unifies study documentation for traceability and audit-readiness
Get in touch to hear how migration works
Healthy Volunteer Clinical Trial Data Management
Managing detailed CRFs, labs, and safety evaluations in a tightly scoped Phase I trial.
-
Creates customized forms for daily and event-driven assessments
-
Supports unified tracking of labs, AE reporting, and dosing
-
Enables self-service data access for sponsors and reviewers
Ask us how we scale from small studies to big impact




